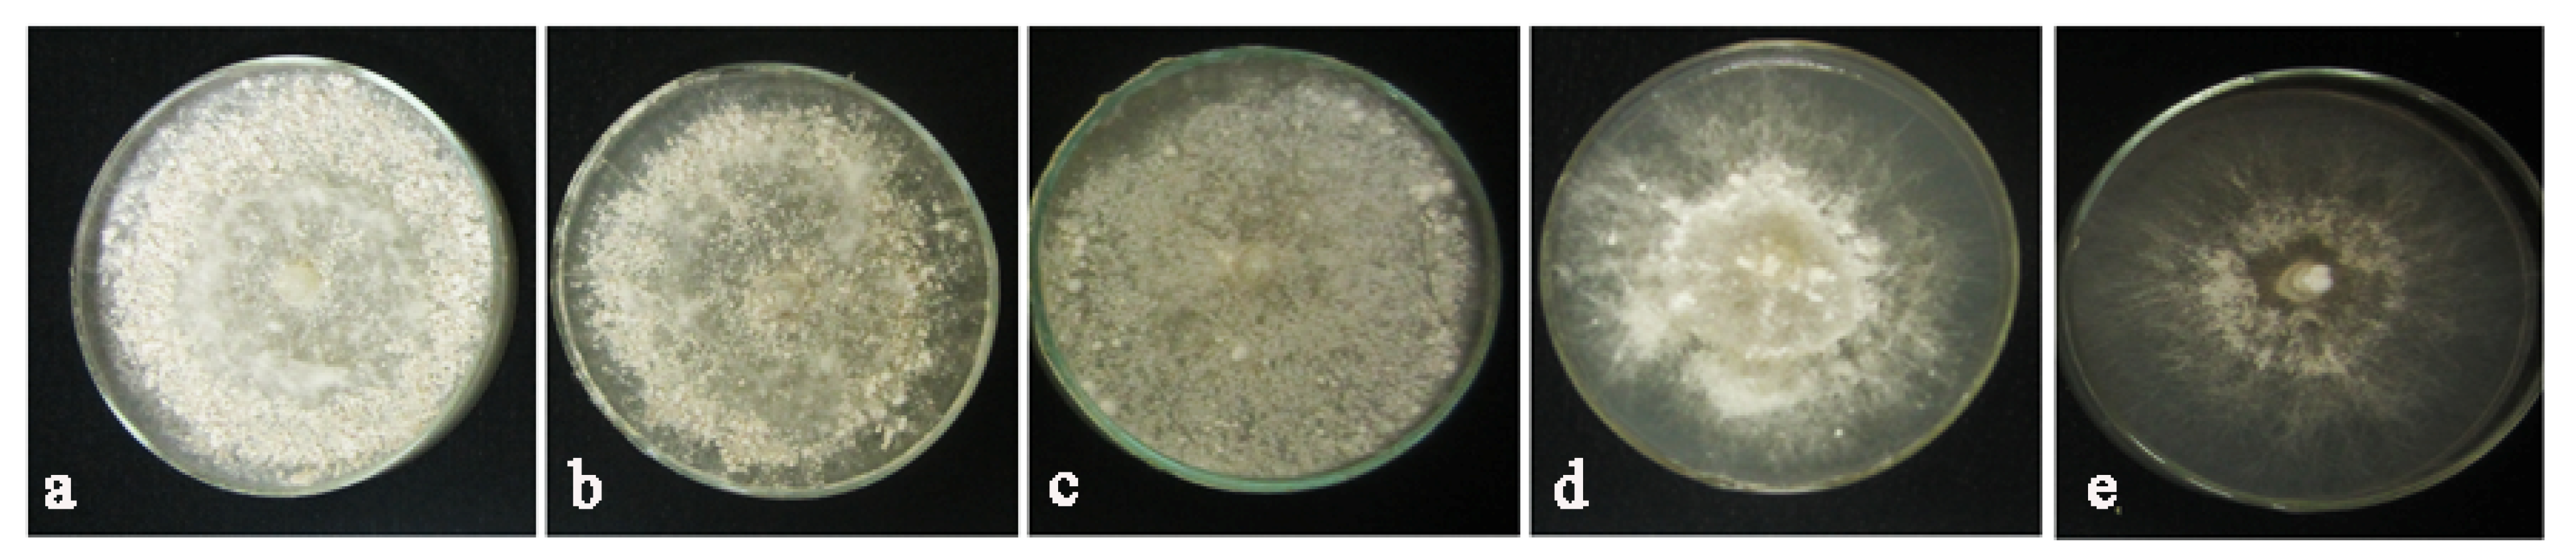
Molecules 27 01181 g010

Evaluation of Phoma sp. Biomass as an Endophytic Fungus for Synthesis of Extracellular Gold Nanoparticles with Antibacterial and Antifungal Properties
Abstract
:1. Introduction
2. Results
2.1. Endophytic Fungi Isolation and Identification of Active Isolate
2.2. Molecular Identification
2.3. Extracellular Biosynthesis of AuNPs
2.4. UV–Vis Analysis
2.5. XRD Analysis
2.6. TEM and DLS Analysis
2.7. FTIR Spectra
2.8. Antibacterial and Antifungal Study
2.9. MIC Analysis
2.10. Inhibitory Effects of AuNPs on Sclerotia of R. solani
3. Discussion
4. Material and Methods
4.1. Isolation and Identification of Endophytic Fungi
4.2. Biosynthesis of Gold Nanoparticles
4.3. UV–Vis Spectroscopy Analysis
4.4. XRD Analysis
4.5. Transmission Electron Microscopy (TEM) Analysis and Dynamic Light Scattering Spectroscopy (DLS)
4.6. Analysis of Fourier Transform Infra-Red Spectroscopy (FTIR)
4.7. Antibacterial and Antifungal Activity
4.8. Determination of Minimum Inhibitory Concentration
4.9. Evaluation of Inhibitory Effects of AuNPs on Sclerotia Formation of Rhizoctonia solani
4.10. Statistical Analysis
Author Contributions
Funding
Institutional Review Board Statement
Informed Consent Statement
Data Availability Statement
Acknowledgments
Conflicts of Interest
Sample Availability
References
- Sousa, A.A.; Schuck, P.; Hassan, S.A. Biomolecular interactions of ultrasmall metallic nanoparticles and nanoclusters. Nanoscale Adv. 2021, 3, 2995–3027. [Google Scholar] [CrossRef] [PubMed]
- Ghosh, M.K.; Sahu, S.; Gupta, I.; Ghorai, T.K. Green synthesis of copper nanoparticles from an extract of Jatropha curcas leaves: Characterization, optical properties, CT-DNA binding and photocatalytic activity. RSC Adv. 2020, 10, 22027–22035. [Google Scholar] [CrossRef]
- Lee, K.X.; Shameli, K.; Yew, Y.P.; Teow, S.-Y.; Jahangirian, H.; Rafiee-Moghaddam, R.; Webster, T.J. Recent developments in the facile bio-synthesis of gold nanoparticles (AuNPs) and their biomedical applications. Int. J. Nanomed. 2020, 15, 275. [Google Scholar] [CrossRef] [PubMed]
- Prucek, R.; Panáček, A.; Gajdová, Ž.; Večeřová, R.; Kvítek, L.; Gallo, J.; Kolář, M. Specific detection of Staphylococcus aureus infection and marker for Alzheimer disease by surface enhanced Raman spectroscopy using silver and gold nanoparticle-coated magnetic polystyrene beads. Sci. Rep. 2021, 11, 1–11. [Google Scholar] [CrossRef]
- Porret, E.; Le Guével, X.; Coll, J.-L. Gold nanoclusters for biomedical applications: Toward In Vivo studies. J. Mater. Chem. B 2020, 8, 2216–2232. [Google Scholar] [CrossRef]
- Chen, Y.; Yang, J.; Fu, S.; Wu, J. Gold Nanoparticles as Radiosensitizers in Cancer Radiotherapy. Int. J. Nanomed. 2020, 15, 9407. [Google Scholar] [CrossRef] [PubMed]
- Sharifi, M.; Hosseinali, S.H.; Alizadeh, R.H.; Hasan, A.; Attar, F.; Salihi, A.; Shekha, M.S.; Amen, K.M.; Aziz, F.M.; Saboury, A.A. Plasmonic and chiroplasmonic nanobiosensors based on gold nanoparticles. Talanta 2020, 212, 120782. [Google Scholar] [CrossRef] [PubMed]
- Huang, X.; Zhu, Y.; Kianfar, E. Nano Biosensors: Properties, applications and electrochemical techniques. J. Mater. Res. Technol. 2021, 12, 1649–1672. [Google Scholar] [CrossRef]
- Atchudan, R.; Edison, T.N.J.I.; Perumal, S.; Karthik, N.; Karthikeyan, D.; Shanmugam, M.; Lee, Y.R. Concurrent synthesis of nitrogen-doped carbon dots for cell imaging and ZnO@ nitrogen-doped carbon sheets for photocatalytic degradation of methylene blue. J. Photochem. Photobiol. A Chem. 2018, 350, 75–85. [Google Scholar] [CrossRef]
- Menon, S.; Rajeshkumar, S.; Kumar, V. A review on biogenic synthesis of gold nanoparticles, characterization, and its applications. Resour-Effic. Technol. 2017, 3, 516–527. [Google Scholar] [CrossRef]
- Qiu, R.; Xiong, W.; Hua, W.; He, Y.; Sun, X.; Xing, M.; Wang, L. A biosynthesized gold nanoparticle from Staphylococcus aureus as a functional factor in muscle tissue engineering. Appl. Mater. Today 2021, 22, 100905. [Google Scholar] [CrossRef]
- Soltani Nejad, M.; Khatami, M.; Bonjar, G.H.S. Extracellular synthesis gold nanotriangles using biomass of Streptomyces microflavus. IET Nanobiotechnol. 2016, 10, 33–38. [Google Scholar] [CrossRef] [PubMed]
- Abu-Tahon, M.A.; Ghareib, M.; Abdallah, W.E. Environmentally benign rapid biosynthesis of extracellular gold nanoparticles using Aspergillus flavus and their cytotoxic and catalytic activities. Process Biochem. 2020, 95, 1–11. [Google Scholar] [CrossRef]
- Ali Dheyab, M.; Aziz, A.A.; Jameel, M.S. Recent Advances in Inorganic Nanomaterials Synthesis Using Sonochemistry: A Comprehensive Review on Iron Oxide, Gold and Iron Oxide Coated Gold Nanoparticles. Molecules 2021, 26, 2453. [Google Scholar] [CrossRef] [PubMed]
- Pant, S.; Mishra, D.; Gupta, S.; Chaturvedi, P. Fungal endophytes as a potential source of therapeutically important metabolites. In Fungi Bio-Prospects in Sustainable Agriculture, Environment and Nano-Technology; Elsevier: Amsterdam, The Netherlands, 2021; pp. 275–314. [Google Scholar]
- Dhayanithy, G.; Subban, K.; Chelliah, J. Diversity and biological activities of endophytic fungi associated with Catharanthus roseus. BMC Microbiol. 2019, 19, 1–14. [Google Scholar] [CrossRef] [PubMed]
- Huang, W.-Y.; Cai, Y.-Z.; Xing, J.; Corke, H.; Sun, M. A potential antioxidant resource: Endophytic fungi from medicinal plants. Econ. Bot. 2007, 61, 14–30. [Google Scholar] [CrossRef]
- Kusari, S.; Hertweck, C.; Spiteller, M. Chemical ecology of endophytic fungi: Origins of secondary metabolites. Chem. Biol. 2012, 19, 792–798. [Google Scholar] [CrossRef] [Green Version]
- Clarance, P.; Luvankar, B.; Sales, J.; Khusro, A.; Agastian, P.; Tack, J.-C.; Al Khulaifi, M.M.; Al-Shwaiman, H.A.; Elgorban, A.M.; Syed, A. Green synthesis and characterization of gold nanoparticles using endophytic fungi Fusarium solani and its in vitro anticancer and biomedical applications. Saudi J. Biol. Sci. 2020, 27, 706–712. [Google Scholar] [CrossRef]
- Manjunath, H.M.; Joshi, C.G.; Raju, N.G. Biofabrication of gold nanoparticles using marine endophytic fungus Penicillium citrinum. IET Nanobiotechnol. 2017, 11, 40–44. [Google Scholar] [CrossRef]
- Bhambure, R.; Bule, M.; Shaligram, N.; Kamat, M.; Singhal, R. Extracellular biosynthesis of gold nanoparticles using Aspergillus niger its characterization and stability. Chem. Eng. Technol. Ind. Chem.-Plant Equip.-Process Eng-Biotechnol. 2009, 32, 1036–1041. [Google Scholar] [CrossRef]
- Lee, K.; Nagajyothi, P.; Sreekanth, T.; Park, S. Eco-friendly synthesis of gold nanoparticles (AuNPs) using Inonotus obliquus and their antibacterial, antioxidant and cytotoxic activities. J. Ind. Eng. Chem. 2015, 26, 67–72. [Google Scholar] [CrossRef]
- Xie, J.; Lee, J.Y.; Wang, D.I.; Ting, Y.P. High-yield synthesis of complex gold nanostructures in a fungal system. J. Phys. Chem. C 2007, 111, 16858–16865. [Google Scholar] [CrossRef]
- Saratale, R.G.; Saratale, G.D.; Shin, H.S.; Jacob, J.M.; Pugazhendhi, A.; Bhaisare, M.; Kumar, G. New insights on the green synthesis of metallic nanoparticles using plant and waste biomaterials: Current knowledge, their agricultural and environmental applications. Environ. Sci. Pollut. Res. 2018, 25, 10164–10183. [Google Scholar] [CrossRef] [PubMed]
- Castillo-Henríquez, L.; Alfaro-Aguilar, K.; Ugalde-Álvarez, J.; Vega-Fernández, L.; Montes de Oca-Vásquez, G.; Vega-Baudrit, J.R. Green synthesis of gold and silver nanoparticles from plant extracts and their possible applications as antimicrobial agents in the agricultural area. Nanomaterials 2020, 10, 1763. [Google Scholar] [CrossRef] [PubMed]
- Lamsal, K.; Kim, S.W.; Jung, J.H.; Kim, Y.S.; Kim, K.S.; Lee, Y.S. Application of silver nanoparticles for the control of Colletotrichum species in vitro and pepper anthracnose disease in field. Mycobiology 2011, 39, 194–199. [Google Scholar] [CrossRef] [Green Version]
- Alghuthaymi, M.A.; Almoammar, H.; Rai, M.; Said-Galiev, E.; Abd-Elsalam, K.A. Myconanoparticles: Synthesis and their role in phytopathogens management. Biotechnol. Biotechnol. Equip. 2015, 29, 221–236. [Google Scholar] [CrossRef] [PubMed]
- Singh, A.; Singh, N.; Hussain, I.; Singh, H.; Singh, S. Plant-nanoparticle interaction: An approach to improve agricultural practices and plant productivity. Int. J. Pharm. Sci. Invent. 2015, 4, 25–40. [Google Scholar]
- Lang, J.M.; Pérez-Quintero, A.L.; Koebnik, R.; DuCharme, E.; Sarra, S.; Doucoure, H.; Keita, I.; Ziegle, J.; Jacobs, J.M.; Oliva, R. A pathovar of Xanthomonas oryzae infecting wild grasses provides insight into the evolution of pathogenicity in rice agroecosystems. Front. Plant Sci. 2019, 10, 507. [Google Scholar] [CrossRef]
- Soltani Nejad, M.; Bonjar, G.H.S.; Khatami, M.; Amini, A.; Aghighi, S. In vitro and in vivo antifungal properties of silver nanoparticles against Rhizoctonia solani, a common agent of rice sheath blight disease. IET Nanobiotechnol. 2017, 11, 236–240. [Google Scholar] [CrossRef]
- Ghasemi-Sardareh, R.; Mohammadi, H. Characterization and pathogenicity of fungal trunk pathogens associated with declining of neem (Azadirachta indica A. Juss) trees in Iran. J. Plant Pathol. 2020, 102, 1159–1171. [Google Scholar] [CrossRef]
- Espinosa-Cristóbal, L.F.; Martínez-Castañón, G.A.; Martínez-Martínez, R.E.; Loyola-Rodríguez, J.P.; Patiño-Marín, N.; Reyes-Macías, J.F.; Ruiz, F. Antibacterial effect of silver nanoparticles against Streptococcus mutans. Mater. Lett. 2009, 63, 2603–2606. [Google Scholar] [CrossRef]
- Sharma, P.; Pant, S.; Rai, S.; Yadav, R.B.; Dave, V. Green Synthesis of Silver Nanoparticle Capped with Allium cepa and Their Catalytic Reduction of Textile Dyes: An Ecofriendly Approach. J. Polym. Environ. 2018, 26, 1795–1803. [Google Scholar] [CrossRef]
- Shunmugam, R.; Renukadevi Balusamy, S.; Kumar, V.; Menon, S.; Lakshmi, T.; Perumalsamy, H. Biosynthesis of gold nanoparticles using marine microbe (Vibrio alginolyticus) and its anticancer and antioxidant analysis. J. King Saud Univ-Sci. 2021, 33, 101260. [Google Scholar] [CrossRef]
- Baker, S.; Satish, S. Biosynthesis of gold nanoparticles by Pseudomonas veronii AS41G inhabiting Annona squamosa L. Spectrochim. Acta Part A Mol. Biomol. Spectrosc. 2015, 150, 691–695. [Google Scholar] [CrossRef] [PubMed]
- Soltanzadeh, M.; Soltani Nejad, M.; Shahidi Bonjar, G.H. Application of Soil-borne Actinomycetes for Biological Control against Fusarium Wilt of Chickpea (Cicer arietinum) caused by Fusarium solani fsp pisi. J. Phytopathol. 2016, 164, 967–978. [Google Scholar] [CrossRef]
- Girard, V.; Dieryckx, C.; Job, C.; Job, D. Secretomes: The fungal strike force. Proteomics 2013, 13, 597–608. [Google Scholar] [CrossRef]
- Abdel-Kareem, M.M.; Zohri, A.A. Extracellular mycosynthesis of gold nanoparticles using Trichoderma hamatum: Optimization, characterization and antimicrobial activity. Lett. Appl. Microbiol. 2018, 67, 465–475. [Google Scholar] [CrossRef]
- Kitching, M.; Ramani, M.; Marsili, E. Fungal biosynthesis of gold nanoparticles: Mechanism and scale up. Microb. Biotechnol. 2015, 8, 904–917. [Google Scholar] [CrossRef]
- Elegbede, J.A.; Lateef, A.; Azeez, M.A.; Asafa, T.B.; Yekeen, T.A.; Oladipo, I.C.; Aina, D.A.; Beukes, L.S.; Gueguim-Kana, E.B. Biofabrication of Gold Nanoparticles Using Xylanases Through Valorization of Corncob by Aspergillus niger and Trichoderma longibrachiatum: Antimicrobial, Antioxidant, Anticoagulant and Thrombolytic Activities. Waste Biomass Valorization 2020, 11, 781–791. [Google Scholar] [CrossRef]
- Ovais, M.; Khalil, A.T.; Ayaz, M.; Ahmad, I.; Nethi, S.K.; Mukherjee, S. Biosynthesis of Metal Nanoparticles via Microbial Enzymes: A Mechanistic Approach. Int. J. Mol. Sci. 2018, 19, 4100. [Google Scholar] [CrossRef] [Green Version]
- Gu, X.; Xu, Z.; Gu, L.; Xu, H.; Han, F.; Chen, B.; Pan, X. Preparation and antibacterial properties of gold nanoparticles: A review. Environ. Chem. Lett. 2020, 19, 1–21. [Google Scholar] [CrossRef]
- Akintelu, S.A.; Yao, B.; Folorunso, A.S. Green synthesis, characterization, and antibacterial investigation of synthesized gold nanoparticles (AuNPs) from Garcinia kola pulp extract. Plasmonics 2021, 16, 157–165. [Google Scholar] [CrossRef]
- Mai-Prochnow, A.; Clauson, M.; Hong, J.; Murphy, A.B. Gram positive and Gram negative bacteria differ in their sensitivity to cold plasma. Sci. Rep. 2016, 6, 1–11. [Google Scholar] [CrossRef] [PubMed] [Green Version]
- Katas, H.; Lim, C.S.; Nor Azlan, A.Y.H.; Buang, F.; Mh Busra, M.F. Antibacterial activity of biosynthesized gold nanoparticles using biomolecules from Lignosus rhinocerotis and chitosan. Saudi Pharm. J. 2019, 27, 283–292. [Google Scholar] [CrossRef]
- Parasuraman, P.; Anju, V.T.; Sruthil Lal, S.B.; Sharan, A.; Busi, S.; Kaviyarasu, K.; Arshad, M.; Dawoud, T.M.S.; Syed, A. Synthesis and antimicrobial photodynamic effect of methylene blue conjugated carbon nanotubes on E. coli and S. aureus. Photochem. Photobiol. Sci. 2019, 18, 563–576. [Google Scholar] [CrossRef]
- Sathiyaraj, S.; Suriyakala, G.; Dhanesh Gandhi, A.; Babujanarthanam, R.; Almaary, K.S.; Chen, T.-W.; Kaviyarasu, K. Biosynthesis, characterization, and antibacterial activity of gold nanoparticles. J. Infect. Public Health 2021, 14, 1842–1847. [Google Scholar] [CrossRef]
- Boruah, J.S.; Devi, C.; Hazarika, U.; Bhaskar Reddy, P.V.; Chowdhury, D.; Barthakur, M.; Kalita, P. Green synthesis of gold nanoparticles using an antiepileptic plant extract: In vitro biological and photo-catalytic activities. RSC Adv. 2021, 11, 28029–28041. [Google Scholar] [CrossRef]
- Hammami, I.; Alabdallah, N.M.; Jomaa, A.A.; Kamoun, M. Gold nanoparticles: Synthesis properties and applications. J. King Saud Univ-Sci. 2021, 33, 101560. [Google Scholar] [CrossRef]
- Molnár, Z.; Bódai, V.; Szakacs, G.; Erdélyi, B.; Fogarassy, Z.; Sáfrán, G.; Varga, T.; Kónya, Z.; Tóth-Szeles, E.; Szűcs, R.; et al. Green synthesis of gold nanoparticles by thermophilic filamentous fungi. Sci. Rep. 2018, 8, 3943. [Google Scholar] [CrossRef]
- Siddiqi, K.S.; Husen, A. Fabrication of Metal Nanoparticles from Fungi and Metal Salts: Scope and Application. Nanoscale Res. Lett. 2016, 11, 98. [Google Scholar] [CrossRef] [Green Version]
- Torabi, A.; Shahidi Bonjar, G.H.; Abdolshahi, R.; Pournamdari, M.; Saadoun, I.; Barka, E.A. Biological control of Paecilomyces formosus, the causal agent of dieback and canker diseases of pistachio by two strains of Streptomyces misionensis. Biol. Control 2019, 137, 104029. [Google Scholar] [CrossRef]
- Akbarpour, N.; Mohammadi, H.; Farahmand, H. Botryosphaeriaceae species involved in crown and root rot of English ivy (Hedera helix L.). Australas. Plant Pathol. 2021, 50, 469–480. [Google Scholar] [CrossRef]
- Barnawi, N.; Allehyani, S.; Seoudi, R. Biosynthesis and characterization of gold nanoparticles and its application in eliminating nickel from water. J. Mater. Res. Technol. 2022, 17, 537–545. [Google Scholar] [CrossRef]
- Soltani Nejad, M.; Shahidi Bonjar, G.; Khaleghi, N. Biosynthesis of gold Nanoparticles using Streptomyces Fulvissimus isolate. Nanomed. J. 2015, 2, 153–159. [Google Scholar]
- Muniyappan, N.; Pandeeswaran, M.; Amalraj, A. Green synthesis of gold nanoparticles using Curcuma pseudomontana isolated curcumin: Its characterization, antimicrobial, antioxidant and anti inflammatory activities. Environ. Chem. Ecotoxicol. 2021, 3, 117–124. [Google Scholar] [CrossRef]
- González-Ballesteros, N.; Torres, M.D.; Flórez-Fernández, N.; Diego-González, L.; Simón-Vázquez, R.; Rodríguez-Argüelles, M.C.; Domínguez, H. Eco-friendly extraction of Mastocarpus stellatus carrageenan for the synthesis of gold nanoparticles with improved biological activity. Int. J. Biol. Macromol. 2021, 183, 1436–1449. [Google Scholar]
- Khatami, M.; Nejad, M.S.; Salari, S.; Almani, P.G. Plant-mediated green synthesis of silver nanoparticles using Trifolium resupinatum seed exudate and their antifungal efficacy on Neofusicoccum parvum and Rhizoctonia solani. IET Nanobiotechnol. 2016, 10, 237–243. [Google Scholar] [CrossRef]
- Taghavizadeh Yazdi, M.E.; Khara, J.; Sadeghnia, H.R.; Esmaeilzadeh Bahabadi, S.; Darroudi, M. Biosynthesis, characterization, and antibacterial activity of silver nanoparticles using Rheum turkestanicum shoots extract. Res. Chem. Intermed. 2018, 44, 1325–1334. [Google Scholar]
- Akhlaghi, M.; Tarighi, S.; Taheri, P. Effects of plant essential oils on growth and virulence factors of Erwinia amylovora. J. Plant Pathol. 2020, 102, 409–419. [Google Scholar] [CrossRef]

Publisher’s Note: MDPI stays neutral with regard to jurisdictional claims in published maps and institutional affiliations. |
© 2022 by the authors. Licensee MDPI, Basel, Switzerland. This article is an open access article distributed under the terms and conditions of the Creative Commons Attribution (CC BY) license (https://creativecommons.org/licenses/by/4.0/).
Share and Cite
Soltani Nejad, M.; Samandari Najafabadi, N.; Aghighi, S.; Pakina, E.; Zargar, M. Evaluation of Phoma sp. Biomass as an Endophytic Fungus for Synthesis of Extracellular Gold Nanoparticles with Antibacterial and Antifungal Properties. Molecules 2022, 27, 1181. https://doi.org/10.3390/molecules27041181
Soltani Nejad M, Samandari Najafabadi N, Aghighi S, Pakina E, Zargar M. Evaluation of Phoma sp. Biomass as an Endophytic Fungus for Synthesis of Extracellular Gold Nanoparticles with Antibacterial and Antifungal Properties. Molecules. 2022; 27(4):1181. https://doi.org/10.3390/molecules27041181
Chicago/Turabian StyleSoltani Nejad, Meysam, Neda Samandari Najafabadi, Sonia Aghighi, Elena Pakina, and Meisam Zargar. 2022. "Evaluation of Phoma sp. Biomass as an Endophytic Fungus for Synthesis of Extracellular Gold Nanoparticles with Antibacterial and Antifungal Properties" Molecules 27, no. 4: 1181. https://doi.org/10.3390/molecules27041181
APA StyleSoltani Nejad, M., Samandari Najafabadi, N., Aghighi, S., Pakina, E., & Zargar, M. (2022). Evaluation of Phoma sp. Biomass as an Endophytic Fungus for Synthesis of Extracellular Gold Nanoparticles with Antibacterial and Antifungal Properties. Molecules, 27(4), 1181. https://doi.org/10.3390/molecules27041181







